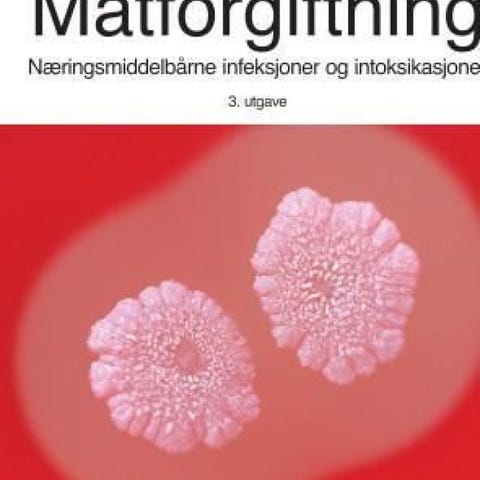

Bildegalleri
(1/1)
Matforgiftning pensumbok
Inaktiv
Til salgs
Fiks ferdig
400 kr
Frakt fra 19 kr + Trygg betaling 45 kr. Frakten er på tilbud – ordinær pris er 38 kr.
Trygg handel med Fiks ferdig
Varen sendes til deg, og du har 24 timer til å inspisere den før pengene overføres til selgeren.
Beskrivelse av varen
Tilstand: Som ny - Ikke synlig brukt
Veldig pent brukt. Ingen markeringer eller synlig slitasje.
NB: Knappen for å vise hele beskrivelsen har kun en visuell effekt.
Brukerprofil

Du må være logget inn for å se brukerprofiler og sende meldinger.
Logg innAnnonsens metadata
Sist endret: 5.2.2026 kl. 18:38 ・ FINN-kode: 449713589
Utforsk våre nye sider for klær og mote
Ta en titt